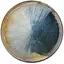
Тарілка десертна 20 cm MADERA - мініатюра 1

Укр
Рус

Код товару: LR_2038597
Інформація про технічні характеристики, комплектацію, склад, країну виготовлення, зовнішній вигляд товару тощо носить довідковий характер і ґрунтується на останніх доступних відомостях від виробника. Для уточнення інформації про товар можна звернутись до колл-центру Продавця або Сайту.
У цього товару ще немає відгуків.
240 ₴
0 800 75 83 68
Безкоштовно з будь-яких номерів
0 44 355 83 68
Дзвінки згідно тарифів вашого оператора
Пн-Нд: 9:00-21:00